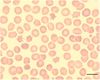

Transfusion Medicine Things to Review Flashcards
(83 cards)
Antigens Enhanced with Enzymes (Ficin, Papain)?
A Rotten Kidd ABO-related ABO-H Lewis System I System P System Rh System Kidd System
Antigens Decreased with Enzyme (Ficin, Papain)?
My Dog Lassie MNS System Duffy System Lutheran System
Dose Dependent Antigens?
Kidd, Duffy, Rh, MNS
Neutralizing Substance: ABO
Saliva (Secretor)
Neutralizing Substance: Lewis
Saliva (secretor for Le^b)
Neutralizing Substance: P1
Hydatid cyst fluid Pigeon egg whites
Neutralizing Substance: Sd^a
Human urine
Neutralizing Substance: Chido, Rodgers
Serum
Determining A1 vs. A2 present?
Dolichos biflorus
Lectin for H Specificity?
Ulex europaeus (causes antigluttination)
Lectin: N Specificity
Vicea graminea
Lectin: T Specificity
Arachis hypogea
Lectin: T, Tn Specificity
Glycine max
Lectin: Tn specificity
Salvia
General: Warm vs. Cold Antibodies
Warm: IgG Exposure HDFN HTRs Significant Cold IgM Naturally Occcuring No HDFN No HTR Insignificant
Type 1 vs. Type 2 Chains
Type 1: Secretion -B1-3 -H is made by FUT2 genes Type 2 Chains: -B1-4 -RBC Membranes H is made by FUT1 genes
Terminal Sugars (A vs. B)
A: GalNac N-acetylgalactosamine B: Gal Galactose
What Chromosome are A,B,O genes on?
Chromosome 9
Different between A and B vs. AB antibodies?
A and B produce IgM antibodies ***Cannot cross the placenta Group O: Anti-A,B is IgG
A1 vs. A2
80% A1 20% A2 A1 has 5x as many antigen than A2 1-2% A2, 25% A2B form anti-A1: Insignificant unless 37 C
Acquired B Phenotype
A1 RBC contact enteric Gram Negative organisms Colon cancer, GI obstruction, Gram(-) sepsis AB forward typing A reverse typing Result of deacytlation of A1 sugar –> making it look like a B sugar
How do you resolve an Acquired B Phenotype?
Acidify serum (pH 6.0) Use monoclonal anti-B that does not recognize acquired B
Bombay Phenotype
Do NOT have an H antigen on the phenotype Have strong anti-A, anti-B, anti-H
Le gene (FUT3)
Allows you to make Lewis A